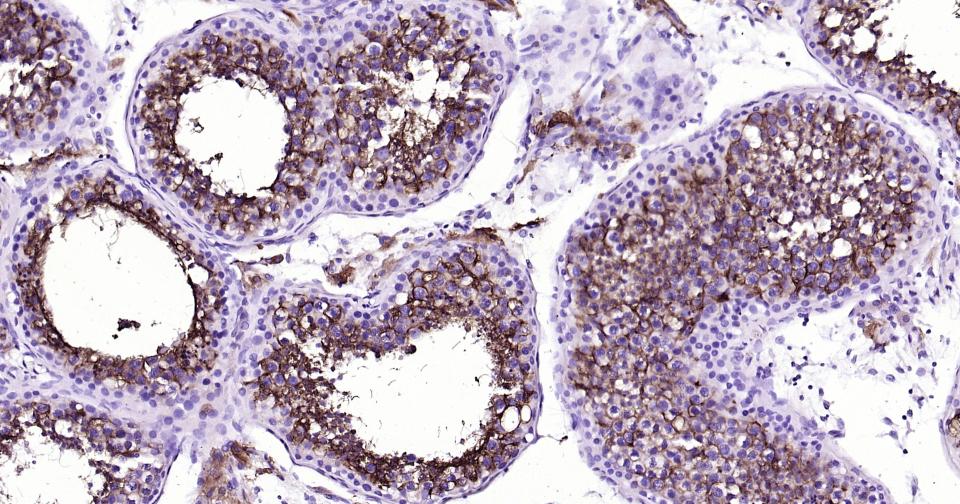
血管紧张素转换酶重组兔单抗

Cardiovascular > Blood > Blood Pressure regulation
Cardiovascular > Heart > Contractility > Inotropics
Cardiovascular > Vasculature > Vasoconstriction
Cell Biology > Proteolysis / Ubiquitin > Proteolytic enzymes > Metalloprotease > ACEs
Microbiology > Organism > Virus > RNA Virus > ssRNA positive strand virus > SARS Coronavirus

| 应用 | 已检合格种属 | 预测种属 | 推荐稀释比例 |
|---|---|---|---|
| WB | Mouse | Human, Rat | 1:500-2000 |
| IHC-P | Human, Mouse, Rat | 1:100-500 | |
| IHC-F | Human, Mouse, Rat | 1:100-500 | |
| IF | Human, Mouse | Rat | 1:100-500 |
| ICC/IF | Human, Mouse, Rat | 1:50-200 |
交叉反应: Human, Mouse, Rat
暂无相关产品
Homodimer (PubMed:32132184).
Interacts with the catalytically active form of TMPRSS2 (PubMed:21068237).
Interacts with SLC6A19; this interaction is essential for expression and function of SLC6A19 in intestine (By similarity).
Interacts with ITGA5:ITGB1 (PubMed:15276642, PubMed:33102950).
Probably interacts (via endocytic sorting signal motif) with AP2M1; the interaction is inhibited by phosphorylation of Tyr-781 (PubMed:33436498).
Interacts (via PDZ-binding motif) with NHERF1 (via PDZ domains); the interaction may enhance ACE2 membrane residence (PubMed:34189428).
(Microbial infection) Interacts with SARS coronavirus/SARS-CoV spike protein.
(Microbial infection) Interacts with SARS coronavirus-2/SARS-CoV-2 spike protein.
(Microbial infection) Interacts with human coronavirus NL63 spike protein.
(Microbial infection) Interacts with human coronavirus NL63/HCoV-NL63 spike glycoprotein.
Processed angiotensin-converting enzyme 2: Secreted. Cell membrane; Single-pass type I membrane protein.
Expressed in endothelial cells from small and large arteries, and in arterial smooth muscle cells (at protein level) (PubMed:15141377).
Expressed in enterocytes of the small intestine, Leydig cells and Sertoli cells (at protein level) (PubMed:15141377).
Expressed in the renal proximal tubule and the small intestine (at protein level) (PubMed:18424768).
Expressed in heart, kidney, testis, and gastrointestinal system (at protein level) (PubMed:10969042, PubMed:10924499, PubMed:15231706, PubMed:12459472, PubMed:15671045, PubMed:32715618, PubMed:32170560).
In lung, expressed at low levels in some alveolar type 2 cells, the expression seems to be individual-specific (at protein level) (PubMed:32425701, PubMed:15141377, PubMed:32715618, PubMed:32170560, PubMed:33432184).
Expressed in nasal epithelial cells (at protein level) (PubMed:33432184, PubMed:32333915).
Coexpressed with TMPRSS2 within some lung alveolar type 2 cells, ileal absorptive enterocytes, intestinal epithelial cells, cornea, gallbladder and nasal goblet secretory cells (PubMed:32413319, PubMed:32327758, PubMed:32358202).
Coexpressed with TMPRSS4 within mature enterocytes (PubMed:32404436).
N-glycosylation on Asn-90 may limit SARS infectivity.
Proteolytic cleavage by ADAM17 generates a secreted form.
Belongs to the peptidase M2 family.
Belongs to the peptidase M2 family.
Essential counter-regulatory carboxypeptidase of the renin-angiotensin hormone system that is a critical regulator of blood volume, systemic vascular resistance, and thus cardiovascular homeostasis (PubMed:27217402).
Converts angiotensin I to angiotensin 1-9, a nine-amino acid peptide with anti-hypertrophic effects in cardiomyocytes, and angiotensin II to angiotensin 1-7, which then acts as a beneficial vasodilator and anti-proliferation agent, counterbalancing the actions of the vasoconstrictor angiotensin II (PubMed:10969042, PubMed:10924499, PubMed:11815627, PubMed:19021774, PubMed:14504186).
Also removes the C-terminal residue from three other vasoactive peptides, neurotensin, kinetensin, and des-Arg bradykinin, but is not active on bradykinin (PubMed:10969042, PubMed:11815627).
Also cleaves other biological peptides, such as apelins (apelin-13, [Pyr1]apelin-13, apelin-17, apelin-36), casomorphins (beta-casomorphin-7, neocasomorphin) and dynorphin A with high efficiency (PubMed:11815627, PubMed:27217402, PubMed:28293165).
In addition, ACE2 C-terminus is homologous to collectrin and is responsible for the trafficking of the neutral amino acid transporter SL6A19 to the plasma membrane of gut epithelial cells via direct interaction, regulating its expression on the cell surface and its catalytic activity (PubMed:18424768, PubMed:19185582).
(Microbial infection) Acts as a receptor for human coronaviruses SARS-CoV and SARS-CoV-2, as well as human coronavirus NL63/HCoV-NL63.